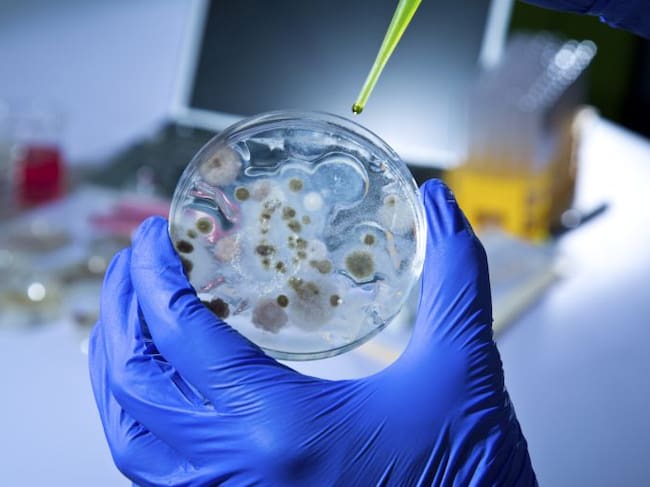

Las secuelas del ébola
El próximo 14 de enero, si no ha habido ningún caso nuevo de ébola en Liberia, la epidemia actual habría terminado. No obstante, la amenaza sigue latente con un virus que todavía es un gran desconocido
Getty Images

Madrid
La actual epidemia de ébola, la más letal de las 25 que se han registrado desde que se produjo el primer contagio hace 40 años, ha afectado a cerca de 29.000 personas en todo el mundo. Se declaró hace dos años en una región al sur de Guinea y, desde entonces, ha acabado con la vida de más de 11.000 contagiados. Esta tragedia ha permitido, sin embargo, estudiar más a fondo la enfermedad y destinar más ayudas a los países afectados. Pero el virus sigue deparando sorpresas a los científicos que estudian su comportamiento.
En ese sentido, los gobiernos de Liberia y Sierra Leona, con el apoyo de la OMS y del Centro para el Control y Prevención de Enfermedades de EEUU, han puesto en marcha una investigación centrada en el semen de 405 hombres supervivientes al contagio. Las células reproductivas masculinas son uno de los reservorios en los que el ébola podía quedar aislado durante semanas, pudiendo generar nuevos contagios. Se han constatado infecciones durante ese periodo, de ahí la importancia de estudiar durante cuánto tiempo puede permancer activo el virus en el semen. De esta forma podría evitarse un rebrote en países ya de por sí asolados por el ébola.
El doctor José Antonio Pérez Molina, miembro de la Sociedad Española de Enfermedades Infecciosas, asegura que "lo que se ha visto con esta epidemia es que algunas de las cosas que se sospechaban, como una transmisión a largo plazo por unas vías diferentes de las que conocemos, parece que es más frecuente de lo que se creía. Y, sobre todo, que, como ha habido miles de personas afectadas, aunque la transmisión por semen sea posible, al haber muchas personas, el número de potenciales transmisores ha crecido. El problema es que esto puede generar microbrotes de virus ébola que antes no se veían".
Secuelas y reactivación
Después de dos años de epidemia con una altísima incidencia, cada vez está más claro que superar la infección de ébola no significa superar la enfermedad. Aunque desaparezcan los síntomas, muchas veces están quedando secuelas que no son para nada menores. Entre esas secuelas están el síndrome de fatiga crónica a largo plazo, los dolores articulares a veces incapacitantes en unas tres cuartas partes de los casos, problemas de visión, o déficit auditivo en casi 1 de cada 5 pacientes.
En algunos casos excepcionales, se ha producido una reactivación del virus en personas a las que ya se daba por curadas. El doctor Pérez Molina señala que "el ébola puede quedar acantonado, escondido en lo que llamamos 'santuarios', que son lugares del organismo en los que la inmunidad no llega de forma tan potente. Esto ha dado lugar a casos de uveítis, que provoca inflamación en la parte anterior del ojo y cambio de color en el iris, o incluso a casos de recaída franca. Es cierto que esto es excepcional, pero de nuevo volvemos a lo mismo: hay que identificar muy bien estos casos y saber cuáles son los pacientes de mayor riesgo, no sólo para curarlos a ellos, sino para que, a partir de ellos, no surjan nuevos brotes".

Carlos Cala
Empieza en la radio en 1992, en la emisora de la Cadena SER en Morón de la Frontera, trabajo que simultanea...




